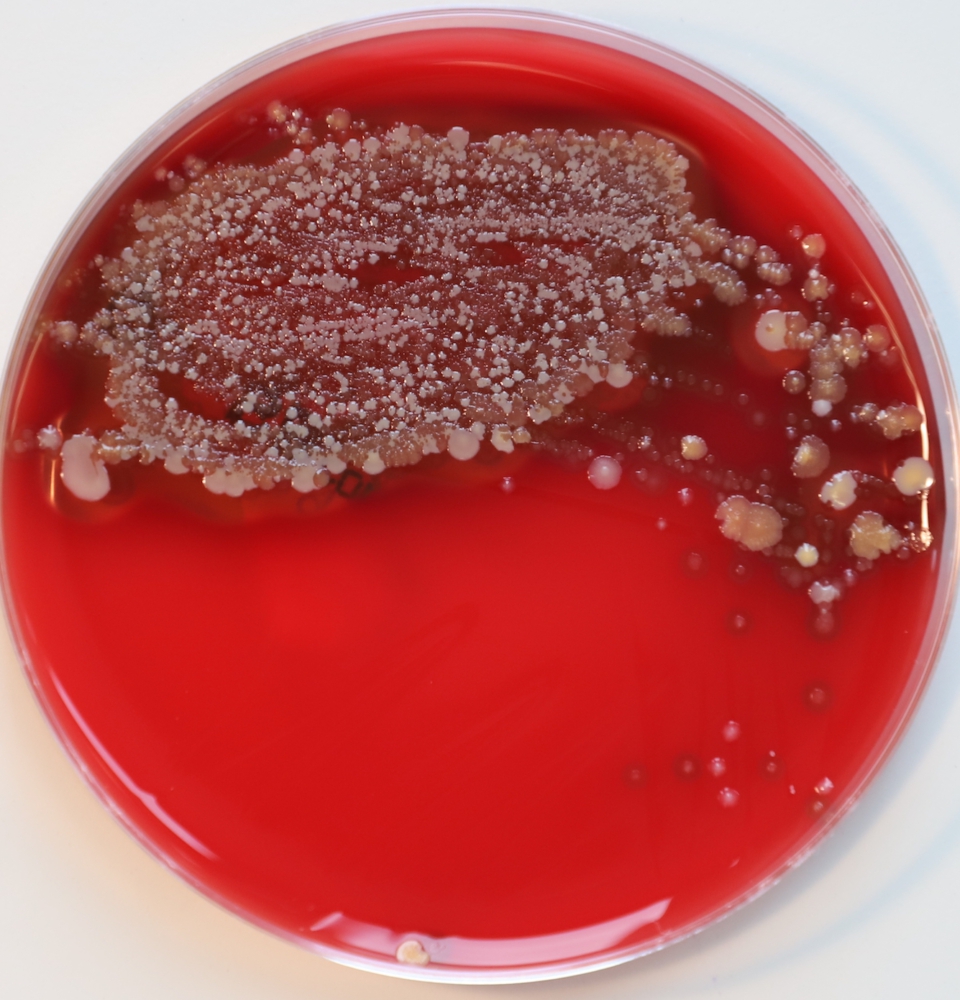

Focus: Health

Great Expectations
Optimistically we swallow the tablet, because it helped last time. Or we take one for the first time and…

In it for the Long Haul
The internationally recognised Heinz Nixdorf Recall Study has been investigating cardiovascular diseases for more than 23 years. There’s no…

Good Killer Cells
Chemotherapy, radiotherapy or surgery – these are the three common forms of cancer therapy. The lymphoma specialists at University…

Please Treat Unequally
Height: just under 1.80 meters; weight: approximately 85 kilograms. One X and one Y chromosome. This has been more…

One Health
What happens deep down in Earth’s subsurface? That’s the focus of Alexander Probst’s research. He also studies how microorganisms…
A Home for Microbes to Share
What lives inside and on our body is the subject of emerging microbiome research. Jan Kehrmann’s team has discovered…

Every Head is Different
Throbbing, wrenching, stabbing: headaches can differ a lot – and almost everyone has them. The West German Headache Center…

The Pulse of Research
A miniscule bacterium can influence whether we are diseased or healthy, a virus or a cell can make the…
Portrait (en)

Finally Everything is Coming Together
It takes four and a half minutes to go between Harry Hoster’s two offices on foot. Those four and…
Highlights (en)

At the Heart of High-Frequency Technology
They can be used to detect skin cancer, determine the water content of a plant, measure material thickness, or…

Knocking on Doors for Science
How do Germans with a family history of immigration vote? Little is known about this, but a team led…

In brief
A summary of key news. GIANT BOLTS AND ARENA ROOFS Cable cars, offshore platforms, wind turbines, the Schalke arena…

Literature Enlivens Predictions
New Perspectives on Climate Change. By Katrin Koster Our future – doomsday scenario or heroic story? When literary texts,…

Got it?
Communicating with AI Systems. By Katrin Koster Homework assistance, health app, or daily planner – with Alexa, Siri, and…

Up not Down
Materials scientists at the UDE want to build new houses from old. Help is coming from an unexpected source…

Captain AI
The roads are full, the rails even more so – that makes transport by water attractive. If it weren’t…

Raw Material for Research
Fewer data silos, more exchange – computer science research is striving for a new data culture. The necessary infrastructure…

Making Baschar, Nele, and Darja Strong
Income poverty, low educational qualifications, poor German language skills, and experiences of migration and displacement – these are challenges faced…
Transfer (en)

A Virus Against Cancer
What if a patient’s own immune system could fight a primary tumour and metastasis – both at once –…
Only here

In the Kingdom of Algae
Island, 1974:Michael Melkonian fishes a sample of the genus Glenodiniopsis out of a small pond, thus marking the beginning…
Printed

Knowledge Between Covers 2023
A small selection of new publications. CURING AN AILING Are we trapped in a schizophrenic time loop? AI is…
Standpoints

Why I Do Research
Four scientists explain what drives them on. »Collaborating as a team to make exciting, new discoveries at the frontier…

